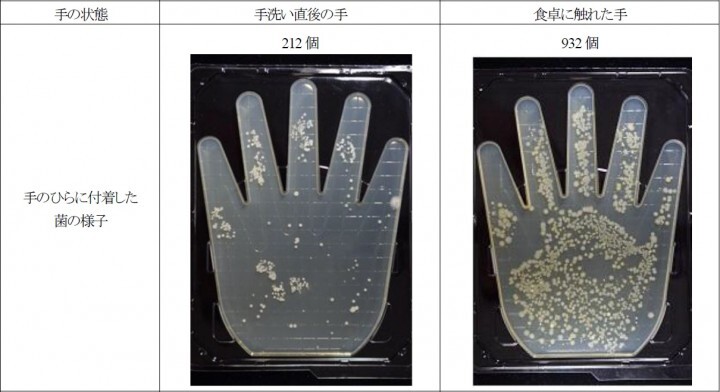
トレンド総研のプレスリリース画像4

梅雨シーズンに要注意の“食卓菌”調査・第2弾 手に約1,000個の“食卓菌”!子供に迫るリスクを解説梅雨から夏のマスト対策、ママに求められる「アルコール除菌」
生活者の意識・実態に関する調査を行うトレンド総研(東京都渋谷区、URL:http://www.trendsoken.com/)と、細菌やカビなどの微生物による環境や健康への影響に関する研究を行う衛生微生物研究センター(東京都葛飾区、URL:http://kabi.co.jp/)は、カビや菌が増殖しやすい梅雨から夏のタイミングに合わせて、食卓に潜む菌、“食卓菌”に関する調査を行いました。
梅雨から夏にかけて気になるカビや食中毒などの菌。その中でも、食卓における菌のリスクを明らかにしつつ、有効な対策を紹介するために、トレンド総研と衛生微生物研究センターは共同で、“食卓菌”に関する調査を行っています。本レポートは、先日2015年6月3日に発表した「台ふきんと食卓菌」に関するレポート(URL:http://www.trendsoken.com/report/health/1703/)に続く第2弾。子供にとっての“食卓菌”のリスクについて行った調査の結果を紹介します。
■1. “食卓菌”の実態に迫る! 主婦500名へアンケート調査を実施
“食卓菌”に関するレポート・第1弾「台ふきんと食卓菌」では、子供がいる家庭において食卓が“食卓菌”に汚染されやすい条件となってしまっていることが分かりました。食後に台ふきんで拭いた直後には、食卓上の10cm四方に100万個以上存在することが明らかになった、食卓菌。食べこぼしが多い子供がいる家庭では台ふきんを使用することも多く、食卓菌に汚染されやすい環境だと言えますが、それだけではありません。身体が小さく、大人に比べると免疫機能の弱い子供のことを考えると、より“食卓菌”への注意を高めなければならないと言えるでしょう。
そこで、子供にとっての“食卓菌”のリスクの実態を探るために、主婦500名を対象に行ったアンケート調査の結果を紹介します。
[調査概要]
調査名:梅雨の“食卓菌”に関する意識・実態調査
調査対象:20代~40代の主婦 500名 ※子供(長子)の年齢により均等割付
・長子が7歳以上の人:100名
・長子が5歳~6歳の人:100名
・長子が3歳~4歳の人:100名
・長子が0歳~2歳の人:100名
・子供がいない人:100名
調査期間:2015年4月27日(月)~2015年4月30日(木)
調査方法:インターネット調査
調査実施機関:楽天リサーチ株式会社
◆子供のいる家庭では要注意の“食卓菌”
前回の調査では、食卓菌の数の多さが明らかになりました。その食卓菌の最大の原因の1つとなっているのが、台ふきんです。しかし、食べこぼしの多い子供がいる家庭では、食べこぼしをサッと拭くことができる台ふきんは重宝するものでしょう。
実際に、今回の調査で、「日常的に、食卓の食べこぼしを台ふきんで拭いている」という人は、子供のいる家庭で73%。子供のいない家庭の56%を3割程度上回る結果となりました。そこで、子供のいる家庭を対象に、その「食べこぼしを台ふきんで拭く頻度」をたずねたところ、「毎食必ず拭いている人」は84%でした。子供のいる家庭では、食卓において台ふきんが多用されていることが明らかになりました。台ふきんで拭いた直後、食卓には、10cm四方に100万個以上の食卓菌が存在します。その状況が食事のたびに再現されていることを考えると、子供のいる家庭における食卓菌のリスクの高さを、改めて感じる結果となったと言えるでしょう。
実際に、子供たちが菌による被害を受けたという人も少なくありません。今回の調査でも、「鳥刺しを食べたら、子供がカンピロバクター菌で食中毒になった。それから生の肉は食べていない。(香川県・49歳)」、「子供が保育園の時にとびひが流行ったが、患部を触った手でおにぎりを握ったため、食中毒になった。(長野県・47歳)」といった意見が見られました。
主婦の間でも、こうした菌の存在を心配する人は多いようです。今回の調査においても、「食卓に菌がいないか気になる」という人は70%を占めました。
免疫力が低い子供にとっては、食卓菌のリスクは大人より大きいものとなります。第1弾の調査においては、食卓に潜んでいる食卓菌の多さが明らかになりましたが、子供にとっては、食卓菌の脅威がことさらに大きなものになるでしょう。食べこぼしたものに食卓菌が付着すれば、それを子供が食べてしまうこともあるでしょう。あるいは、食卓に触れた際に食卓菌が手に付着してしまえば、その手を子供がなめてしまうといったこともあるかもしれません。子供がいるご家庭では、より一層、食卓菌に気をつけてもらいたいものです。
■2. 食べこぼしには要注意! 子供にとっての“食卓菌”のリスクを探る
このように、本調査は、子供にとっての食卓菌のリスクの大きさをうかがい知ることができる結果となりました。そこで、子供にとっての食卓菌のリスクにフォーカスし、衛生微生物研究センターにて実験を行いました。「梅雨の“食卓菌”調査」の第1弾として発表した「台ふきんと食卓菌」に関するレポートでも紹介しましたが、食卓や台ふきんには、沢山の“食卓菌”が潜んでいる可能性があります。今回は、こうした“食卓菌”が子供に接触する危険性を定量的に示します。
◆ 台ふきんを多用する子供がいる家庭は要注意! 水拭きで増える“食卓菌”の実態とは!?
今回の実験では、想定される一般の家庭での食卓の状況を再現し、その時に、食卓に触れた子供の手に付着する食卓菌のリスクを知るために、その手に付着する食卓菌の数を調べました。
[実験の説明]
<想定する一般家庭>
1週間に1回程度、台ふきんを漂白する家庭を想定し、台ふきんで拭いた食卓を子供が触ったとして、その子供の手につく食卓菌の数を計測しました。なお、実験時に食卓を触る際には、事前に、市販の洗浄液で十分に手洗いを行いました。また、汚染された台ふきんの作製方法は以下の通りです。
清潔な台ふきんを肉、魚および野菜の食べカスを混ぜた水に1日1回浸した後、水道水でもみ洗いし、水を絞った上で、梅雨時を想定した気温25℃、相対湿度80%の環境で放置しました。これを7日間繰り返し、汚染された台ふきんを再現しました。
<実験方法>
Step 1
市販の洗浄液で十分に手洗いを行います。その後、その手のひらの雑菌数を測定しましました。
Step 2
汚染された台ふきんで食卓を水拭きしました。
市販の洗浄液で十分に手洗いを行った状態の手で食卓に触れ、その手のひらの雑菌数を測定しました。
その結果、食卓に触れることで、“食卓菌”が手のひらに付着し、手のひらの菌数が増加する様子が明確に見られました。
◆ 梅雨の“食卓菌”対策のマストアイテムはアルコール除菌! 子供“食卓菌”リスクを解説
<衛生微生物研究センター 所長 李 憲俊>
今回の実験では、食卓上の菌が、食卓に触れた子供の手に付着する様子を調べました。手を洗った後には、手のひらに付着した菌は212個でしたが、食卓に触れた後には、4.4倍の932個に増加。食卓に触れた手の菌の培養効果を見てもらえば、手のひらにびっしりと菌が付着していることがはっきりと確認することができます。
このように、食卓上にいる菌は手のひらに付着することが分かると、次に気になるのが、菌が体内に侵入するリスクです。特に、子供のいる家庭では、注意が必要だと言えます。好奇心豊かな子供たちは、食卓を触る機会も多いでしょう。その手をなめてしまったり、その手で食べ物を掴んで食べたりすれば、手のひらに付着した菌が体内に入ってしまいます。体内に侵入した菌の種類によっては、食中毒を発症します。
今回のアンケート調査でも様々な菌が知られていることが分かりましたが、これらの菌は、実際に食卓にいる可能性があります。
代表的なところをいくつか紹介しましょう。
これからの季節、夏場に注意が必要なものの1つには、鶏卵や鶏肉から感染することが多いサルモネラ菌があげられます。しっかり加熱をすれば死滅させることができるのですが、鶏卵を使い、マヨネーズやアイスクリームをご自宅で作る人などは注意が必要でしょう。また、肉類に多いのは、カンピロバクター菌です。サルモネラ菌と同様に熱で処理すれば死滅させられますが、調理時に使用した台ふきんを食卓でも使う時などは、注意が必要でしょう。また、トイレに行った後に十分に手を洗えていないと、その時に付着した大腸菌が食卓から検出されるということもあります。こうした菌はいずれも、食中毒のリスクをもっています。
梅雨から夏の季節は、食中毒の増える季節でもあります。子供や高齢者などは、食中毒で下痢や嘔吐が続くと容易に脱水症状を引き起こし、最悪の場合命に関わるようなこともあります。子供のいる家庭では、主婦の方にしっかりと対策を行ってもらいたいと思います。
食卓は食事をする場所であるため、食中毒の原因菌に汚染されていた場合、体内へ入れてしまう危険性があります。食中毒のリスクを下げるためには、汚染された場所を除菌することが必要です。有効な対策の1つとして、アルコールでの除菌があげられます。特に、子供は、食事中も様々なところを触ったり、食べこぼしてしまったりするものでしょう。食卓に多くの菌がいれば、今回の実験のように、子供たちの手にも菌が付着してしまいます。
実際に、「台ふきんと食卓菌」に関するレポート(URL:http://www.trendsoken.com/report/health/1703/)では、食卓におけるアルコール除菌の有効性を確認することができました。この実験では、汚染された台ふきんで食卓を拭いた直後、食卓には10cm四方に約340万の食卓菌が存在することが分かりました。しかし、アルコール除菌を行うと食卓菌の数は10個未満となり、大幅に減らせることが確認できました。
食事の際は、菌が体内に侵入するリスクも高いと言えます。食事の前には、アルコール除菌を行い、食卓を清潔に保ちましょう。また、食事の後にも、食べこぼしなどの汚れを拭きとり、水気をしっかりとるようにしましょう。その上で、アルコールできちんと除菌することが大切です。気温も湿度も高い梅雨から夏にかけての季節は、菌が繁殖しやすい時期です。食卓における菌のリスクもいっそう高まります。だからこそ、しっかりと対策を行うことが重要です。
◆李 憲俊 (り のりとし)
-研究者-
環境や工業製品の汚染微生物の分布や特徴について研究する研究者。
カビや微生物に関する研究を行う、衛生微生物研究センターの所長を務める。
韓国国立忠南大学助教授を経て、1991年、(財)食品薬品安全センター秦野研究所微生物学研究室に入所。
1996年に(株)衛生微生物研究センターを開設し、所長に就任。
NHK「ためしてガッテン」や民放で、汚染微生物対策をテーマとしたテレビ番組にも多数出演。
衛生微生物研究センター HP
添付画像・資料
添付画像をまとめてダウンロード
企業情報
| 企業名 | トレンド総研 |
|---|---|
| 代表者名 | ---- |
| 業種 | その他サービス |
コラム
トレンド総研の
関連プレスリリース
-
~トレンド総研 レポート~ 値上げの春…食料品だけでなく電気料金にも値上げの波! 燃料費下落の影で、上昇し続ける「再エネ賦課金」
2019年5月28日 14時
-
母親たちへの調査で、意外な「風邪予防」のポイントが判明! 家庭での“野菜摂取量”が少ない子どもほど、風邪をひきやすい傾向に!?
2018年12月13日 14時
-
~11月14日は世界糖尿病デー~ 健康診断では「正常」のはずが…見えない「異変」の恐怖 現代人の新たな脅威「血糖値スパイク」とは?
2018年11月8日 13時
-
~家庭での調理トレンドに新たな波が登場~ 「コスパ」「時短」の次は「栄養効率」に注目!? キーワードは「ヘルスパフォーマンス」
2018年10月17日 12時
トレンド総研の
関連プレスリリースをもっと見る